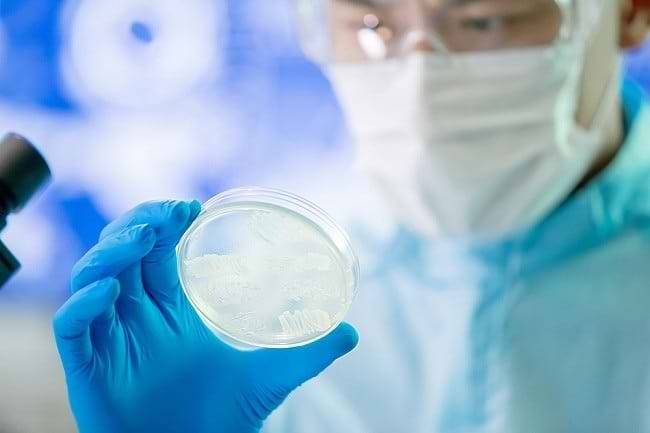
Kenali Seputar Mutasi Virus dan Penyebab Terjadinya - Alodokter

Mutasi virus adalah perubahan struktur dan sifat genetik virus. Proses ini dapat terjadi ketika virus sedang memperbanyak diri di dalam sel tubuh inangnya, baik manusia maupun hewan. Namun, apa yang menyebabkan virus bermutasi?
Virus merupakan mikroorganisme yang berukuran sangat kecil, yaitu sekitar 16–30 nanometer. Ukuran ini jauh lebih kecil daripada bakteri. Meski demikian, baik bakteri maupun virus, sama-sama dapat menyebabkan infeksi atau penyakit pada manusia.
Berikut ini adalah beberapa jenis penyakit yang disebabkan oleh virus:
- Flu
- Campak
- Hepatitis B dan C
- Cacar air
- Demam berdarah
- HIV/AIDS
- COVID-19
Alasan Virus Bermutasi
Virus bertahan hidup dengan cara menempel pada sel inang. Selama berada di dalam tubuh manusia atau hewan yang menjadi inangnya, virus akan terus berkembang biak dengan menyalurkan materi genetik, baik RNA maupun DNA, ke sel sehat dalam tubuh inangnya.
Setelah materi genetik virus masuk ke dalam sel inang, virus akan menguasai dan merusak sel tersebut. Namun, pada manusia, proses ini bisa dihambat oleh sistem kekebalan tubuh.
Agar dapat bertahan hidup, virus harus beradaptasi dengan selalu bermutasi untuk mengelabui sistem kekebalan tubuh inangnya. Setelah virus bermutasi, sistem kekebalan tubuh akan lebih sulit mengenali virus, sehingga virus dapat tetap bertahan dan menyerang sel inangnya.
Tak hanya untuk mengelabui sistem imunitas, proses mutasi virus juga dapat membuat virus semakin kuat dan lebih mudah berkembang biak. Mutasi virus pun dapat membuat virus berpotensi menyebabkan penyakit baru, misalnya COVID-19.
Meski demikian, virus kadang juga bisa dirangsang untuk bermutasi agar lebih lemah. Proses ini umumnya dilakukan di laboratorium, dengan intervensi manusia. Mutasi virus agar menjadi lebih lemah ini biasanya dilakukan dalam proses pengembangan vaksin.
Mutasi Virus Corona dan Vaksin Corona
Salah satu penyakit yang disebabkan oleh virus adalah COVID-19. Virus Corona penyebab penyakit COVID-19 merupakan jenis virus RNA. Jika dibandingkan virus DNA, virus RNA memang cenderung lebih cepat bermutasi.
Selama beberapa bulan terakhir, virus Corona yang baru muncul di akhir tahun 2019 ini diketahui telah mengalami mutasi. Akan tetapi, pengaruh mutasi virus Corona terhadap tingkat keparahan penyakit, kecepatan penularan virus, serta pengembangan vaksin masih belum dianggap signifikan hingga memerlukan perhatian khusus.
Namun, mulai di penghujun tahun 2020 hingga 2021, WHO telah melaporkan ada beberapa jenis varian virus Corona baru yang perlu diwaspadai (variant of concerns), yaitu virus Corona varian Alpha, Beta, Gamma, dan Delta. Sedangkan beberapa varian COVID-19 lain seperti Kappa, Lambda, Mu, Eta dan Iota diklasifikiasikan sebagai varian yang perlu diperhatikan (variants of interest).
Vaksin untuk virus Corona yang saat ini dikembangkan pun masih efektif untuk merangsang sistem imun dalam melawan virus Corona yang telah mengalami mutasi.
Jika Anda ingin mengetahui lebih banyak informasi terkait gejala, pencegahan, dan fakta tentang virus Corona dan COVID-19, download aplikasi ALODOKTER di Google Play atau App Store.
Melalui aplikasi ALODOKTER, Anda bisa chat langsung dengan dokter dan membuat janji konsultasi dengan dokter di rumah sakit jika memang memerlukan pemeriksaan langsung.